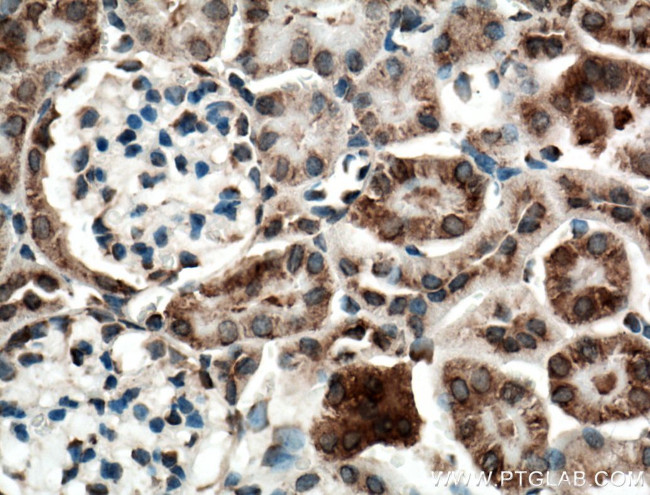
SLC25A10 Antibody in Immunohistochemistry (Paraffin) (IHC (P))

Search
Proteintech
SLC25A10 Polyclonal Antibody
{{$productOrderCtrl.translations['antibody.pdp.commerceCard.promotion.promotions']}}
{{$productOrderCtrl.translations['antibody.pdp.commerceCard.promotion.viewpromo']}}
{{$productOrderCtrl.translations['antibody.pdp.commerceCard.promotion.promocode']}}: {{promo.promoCode}} {{promo.promoTitle}} {{promo.promoDescription}}. {{$productOrderCtrl.translations['antibody.pdp.commerceCard.promotion.learnmore']}}
产品信息
12086-1-AP
种属反应
宿主/亚型
分类
类型
抗原
偶联物
形式
浓度
规格
纯化类型
保存液
内含物
保存条件
运输条件
产品详细信息
Immunogen sequence: MAAEARVSR WYFGGLASCG AACCTHPLDL LKVHLQTQQE VKLRMTGMAL RVVRTDGILA LYSGLSASLC RQMTYSLTRF AIYETVRDRV AKGSQGPLPF HEKVLLGSVS GLAGGFVGTP ADLVNVRMQN DVKLPQGQRR NYAHALDGLY RVAREEGLRR LFSGATMASS RGALVTVGQL SCYDQAKQLV LSTGYLSDNI FTHFVASFIA AAGDEPPPQG GCATFLCQPL DVLKTRLMNS KGEYQGVFHC AVETAKLGPL AFYKGLVPAG IRLIPHTVLT FVFLEQLRKN FGIKVPS (1-296 aa encoded by BC015797)
靶标信息
The mitochondrial dicarboxylate carrier protein (mDIC) belongs to superfamily of mitochondrial transporters. It has been demonstrated that the expression of mDIC leads to hyperpolarization of the mitochondria, as well as succinate uptake by the mitochondria. It is highly expressed in adipose tissue, where its expression is downregulated by insulin and upregulated by free fatty acids. mDIC is also thought to play a role in glyceroneogenesis.
仅用于科研。不用于诊断过程。未经明确授权不得转售。
生物信息学
蛋白别名: DIC; dicarboxylate ion carrier; dicarboxylate transporter), member 10; Mitochondrial dicarboxylate carrier; solute carrier family 25 (mitochondrial carrier; adenine nucleotide translocator), member 10; solute carrier family 25 (mitochondrial carrier; dicarboxylate transporter) member 10 isoform SLC25A10_1; solute carrier family 25 (mitochondrial carrier; dicarboxylate transporter) member 10 isoform SLC25A10_2; solute carrier family 25 (mitochondrial carrier; dicarboxylate transporter) member 10 isoform SLC25A10_3; solute carrier family 25 (mitochondrial carrier; dicarboxylate transporter), member 10; Solute carrier family 25 member 10; unnamed protein product
基因别名: DIC; MTDPS19; SLC25A10
UniProt ID: (Human) Q9UBX3, (Mouse) Q9QZD8, (Rat) O89035
Entrez Gene ID: (Human) 1468, (Mouse) 27376, (Rat) 170943